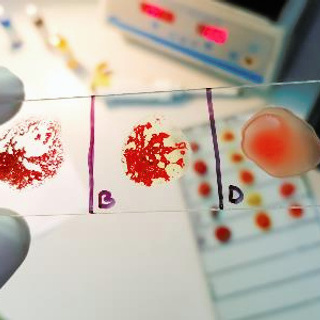
course-image-6685.jpg

Course 5. Antiglobulin tests

About the course
Antihuman globulin tests have several applications in the laboratory. In this course you will learn how antihuman globulin reagents are used to detect whether red cells have been sensitised by immunoglobulin and/or complement. On completing the lessons you will be able to explain why and how cell washing is performed and be able to list investigations that use the direct and indirect antihuman globulin tests across a range of scenarios.
A basic understanding of antigen-antibody reactions and antihuman globulin reagent will help you maximize your learning in this course. This foundation knowledge might be gained through practical experience, pre-reading or by completion of earlier antigen-antibody courses in the ISBT eLearning series.
Course units
The course should require one to two hours to complete, and includes the units:
• The direct antiglobulin test (DAT)
• Cell washing
• The indirect antiglobulin test (IAT)
Target group
This course provides education on antigen-antibody reactions at an introductory level for learners who are entering the field as laboratory technicians, scientists or clinicians and is on topics demonstrated to be of interest and importance in a range of countries.
Evaluation
Each learning unit concludes with a quiz. Each quiz question is linked to one or more learning outcomes for that unit. Quiz performance can be analysed to demonstrate which learning outcomes are being satisfactorily addressed by the educational material, or if revisions to learning content are required to support learning.
Course content source
The course content is based on the peer-reviewed publication Introduction to blood transfusion: from donor to recipient, which is available for free here.